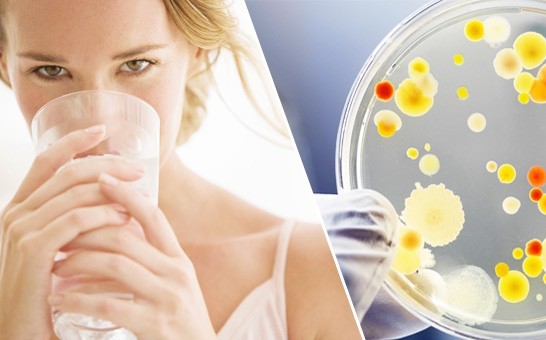

Что такое шлаки и токсины?
Что подразумевается под шлаками и токсинами в организме человека, как от них избавиться?
Все знают, что шлаки и токсины вредны, но немногие представляют, откуда они появляются и как с ними можно бороться.
Все знают, что в процессе жизнедеятельности в организме у человека накапливаются вредные вещества. Они могут накапливаться практически во всех органах, но люди упорно чистят кишечник и свято верят в то, что улучшают собственное здоровье.
Что подразумевается под терминами «шлаки» и «токсины»?
Под шлаками и токсинами подразумеваются вредные вещества, которые накапливаются в организме, а также конечные продукты жизнедеятельности. К ним относятся:
- Соли.
- Оксиды тяжелых металлов.
- Радионуклиды.
- Нитраты.
- Компоненты некоторых лекарственных препаратов.
- Пищевые добавки химического происхождения.

- Генетически модифицированные продукты.
Симптомы зашлакованности организма
Определить наличие шлаков и токсинов в организме можно по следующим признакам:
- Слабость без причины.
- Чувство усталости, утомления (не проходит после сна и отдыха).
- Боли в суставах и мышцах.
- Неприятный запах изо рта.
- Светлый налет на языке.
- Частые головные боли.
- Кожные высыпания неясной природы.
- Болезни, связанные с деформацией органов.
- Доброкачественные и злокачественные новообразования.
- Прогрессирующие заболевания нервной системы.
- Необратимые нарушения тканей и работы внутренних органов.
- Проблемы с походами в туалет.
- Лишний вес.

- Повышенная потливость (пот очень резко и неприятно пахнет).
- Аллергические реакции.
- Проблемы со сном.
- Вздутие живота, метеоризм.
- Частые простудные заболевания.
- Нарушенный обмен веществ.
В каких органах могут скапливаться шлаки и токсины?
Шлаки и токсины часто скапливаются в следующих органах:
- Кишечник. Ворсинки тонкого кишечника забиваются отложениями, поэтому питательные вещества не могут полноценно всасываться.
- Печень и почки. Зашлакованность отражается на их очищающей функции.
- Кровеносные сосуды. Из-за того, что токсины скапливаются на стенках сосудов, по организму хуже циркулируют кровь и питательные вещества.
- Межклеточное пространство и лимфатическая система. Происходят изменения в жировых клетках и тканях, на коже начинает проявляться целлюлит.
Как очистить организм от шлаков и токсинов?
Чистку организма от шлаков и токсинов можно осуществлять при помощи продуктов питания или медикаментозного лечения. Существует две группы препаратов для очистки организма:
Существует две группы препаратов для очистки организма:
- Мочегонные. Способствуют тому, что почки начинают более быстро фильтровать кровь. За счет этого токсины и шлаки выходят вместе с мочой. Это подходит для тех веществ, которые могут просочиться через почечную мембрану.
- Энтеросорбенты. Чистят кишечник от вредной микрофлоры и остатков жизнедеятельности. Частицы препаратов связывают между собой молекулы токсинов и выводят их из организма естественным путем.
Есть продукты, подходящие для мягкого очищения организма:
- Овсяная каша, сваренная на воде.
- Овсяный кисель или отвар.
- Гречневая или пшенная каша.
- Рисовый отвар.
- Кукуруза.
- Продукты с отрубями или отруби в чистом виде.
- Кисломолочные продукты.
- Капуста в любом виде.
- Свежие фрукты и овощи (без нитратов, химикатов и вредных солей, биологически чистые).

Внимание! Во время чистки организма важно соблюдать физическую активность, побольше ходить пешком.
Шлаки и токсины могут скапливаться не только в кишечнике, но и во всем организме. Они существенно нарушают процесс жизнедеятельности, поэтому от них важно вовремя избавляться.
Отказ от ответсвенности
Обращаем ваше внимание, что вся информация, размещённая на сайте
Prowellness предоставлена исключительно в ознакомительных целях и не является персональной программой, прямой рекомендацией к действию или врачебными советами. Не используйте данные материалы для диагностики, лечения или проведения любых медицинских манипуляций. Перед применением любой методики или употреблением любого продукта проконсультируйтесь с врачом. Данный сайт не является специализированным медицинским порталом и не заменяет профессиональной консультации специалиста. Владелец Сайта не несет никакой ответственности ни перед какой стороной, понесший косвенный или прямой ущерб в результате неправильного использования материалов, размещенных на данном ресурсе.
Владелец Сайта не несет никакой ответственности ни перед какой стороной, понесший косвенный или прямой ущерб в результате неправильного использования материалов, размещенных на данном ресурсе.
Нужен ли здоровым людям детокс от «шлаков и токсинов» — Wonderzine
Текст: Алексей Водовозов
ОТВЕТЫ НА БОЛЬШИНСТВО ВОЛНУЮЩИХ НАС ВОПРОСОВ мы все привыкли искать онлайн. В этой серии материалов задаём именно такие вопросы — животрепещущие, неожиданные или распространённые — профессионалам в самых разных сферах.
Такие понятия, как «чистка» или «детоксикация», встречаются практически в любом альтернативном медицинском течении. Если, скажем, к практикам медитации и «очищения» своих мыслей претензий нет, то что касается физического очищения организма, возникают вопросы о необходимости, пользе и возможном вреде такого детокса. Мы поговорили об этом со специалистом.
врач-токсиколог, научный журналист
«Шлаки» и «токсины», от которых предлагают чиститься в альтернативной медицине, — это несуществующая угроза, и никто никогда их не видел.
При этом «альтернативщики» активно используют выдуманную, но наукообразную терминологию — например, описывают «семь степеней зашлакованности по классификации Всемирной организации здравоохранения». Не очень понятно, зачем в таком случае прикрываться именем ВОЗ: достаточно зайти на официальный сайт и попытаться найти поиском слово «зашлакованность», чтобы получить нулевой результат. Ни «зашлакованность», ни «закисленность» — ещё один распространённый диагноз с тёмной стороны медицины — не удаётся найти и на сайте Международной классификации болезней.
Часто используется странный аргумент: официальная наука не может опровергнуть наши утверждения, а значит, мы правы.
«Шлаки» и «токсины», от которых предлагают чиститься в альтернативной медицине, — это несуществующая угроза, и никто никогда их не видел
В 2005 году два новозеландских учёных — клинический биохимик и гастроэнтеролог — решили проверить, из чего же такие камни состоят. К ним в клинику обратилась женщина с настоящими камнями в желчном пузыре, которой травник рекомендовал подобную «чистку»; из пациентки действительно вышли некие образования, которые она собрала, заморозила, а потом принесла для исследования.
Кстати, о хирургии. С некоторыми камнями в желчном пузыре можно прожить всю жизнь. Но если стимулировать печень такими альтернативными методами, камешки могут пойти на выход самостоятельно. Хорошо, если они будут мелкими и пройдут через все протоки и сфинктеры, а если застрянут в узком участке двенадцатиперстной кишки, куда открываются общий желчный проток и проток поджелудочной железы? Остановка оттока желчи покажется цветочками по сравнению с острым панкреонекрозом — разрушением тканей поджелудочной железы её же собственными ферментами. И никакие чистки в такой ситуации не помогут, с ней и врачи-то не всегда в состоянии справиться.
«Чистки» бывают и относительно безобидными, например популярный «детокс» — диета из соков и смузи. Напрямую навредить бутылочки с разноцветным содержимым вряд ли смогут, всё-таки там пищевые продукты. Увлечение жидкой пищей не очень хорошо сказывается на здоровье зубов и более глубоких отделов ЖКТ, но всё-таки крупномасштабных проблем с этой стороны ожидать не стоит. Беда в том, что люди редко ограничиваются бутылочками с «детоксом». Зачастую «чистятся» комплексно. Например, при помощи гидроколонотерапии, которая преподносится как мягкая, натуральная и физиологичная методика, хотя не очень понятно, что физиологичного в закачивании через задний проход под давлением огромных (десятки литров) объёмов воды. Мало того что происходит вымывание микрофлоры кишечника, описаны гораздо более неприятные последствия. Например, перфорация прямой кишки или заражение амёбиазом. Эта процедура не только не решает проблемы, но и создаёт новые. Как и не менее популярная кофейная клизма — описаны случаи перфорации прямой кишки из-за ожогов слизистой горячим кофе, а также летальные исходы. И это не считая таких «мелочей», как нарушения электролитного баланса и полимикробная септицемия.
Напрямую навредить бутылочки с разноцветным содержимым вряд ли смогут, всё-таки там пищевые продукты. Увлечение жидкой пищей не очень хорошо сказывается на здоровье зубов и более глубоких отделов ЖКТ, но всё-таки крупномасштабных проблем с этой стороны ожидать не стоит. Беда в том, что люди редко ограничиваются бутылочками с «детоксом». Зачастую «чистятся» комплексно. Например, при помощи гидроколонотерапии, которая преподносится как мягкая, натуральная и физиологичная методика, хотя не очень понятно, что физиологичного в закачивании через задний проход под давлением огромных (десятки литров) объёмов воды. Мало того что происходит вымывание микрофлоры кишечника, описаны гораздо более неприятные последствия. Например, перфорация прямой кишки или заражение амёбиазом. Эта процедура не только не решает проблемы, но и создаёт новые. Как и не менее популярная кофейная клизма — описаны случаи перфорации прямой кишки из-за ожогов слизистой горячим кофе, а также летальные исходы. И это не считая таких «мелочей», как нарушения электролитного баланса и полимикробная септицемия.
Гидроколонотеарпия преподносится как мягкая и физиологичная методика, хотя не очень понятно, что физиологичного в закачивании через задний проход под давлением огромных объёмов воды
«Натуральные» биодобавки, которые часто включают в комплекс чистки, на поверку оказываются напичканными той самой «страшной аптечной химией», которую БАД вроде бы призваны заменить. Например, всего в восьми различных «травяных» добавках для похудения найдены рецептурные сибутрамин, буметанид, фенитоин, псевдоэфедрин, амфепрамон, обладающие очень тяжёлыми побочными эффектами и применяемые по строгим показаниям, а также канцерогенный и давно снятый с производства фенолфталеин, известный как пурген.
И таких примеров масса. Не имея возможности доказать наличие реальных заболеваний, апологеты альтернативной медицины и их адепты просто постулируют: шлаки есть, надо от них чиститься, не озадачиваясь вопросами обоснованности таких действий. В результате люди вредят себе напрямую или косвенно, не обращаясь к врачам при наличии серьёзной патологии и пытаясь спастись от болезней эфемерной «чисткой».
Когда всё-таки организму требуется «чистка» и от каких веществ? Например, при серьёзных нарушениях работы печени или почек, если они не справляются со своей основной задачей — собственно, устранением токсинов и продуктов переработки из организма. Через почки выводятся метаболиты, возникающие при распаде белков, в том числе мочевина, мочевая кислота, индикан и креатинин. Если почки со своей работой не справляются, эти азотистые шлаки (официальный термин) накапливаются и начинают вредить организму. Способ очистки организма от таких шлаков известен: гемодиализ при помощи аппарата «искусственная почка». Это громоздкое стационарное сооружение, хотя в 2016-м году успешно прошла первую фазу клинических испытаний портативная версия устройства.
Разнообразные токсины тоже неплохо изучены. Со многими из них, например токсинами микроорганизмов, мы регулярно сталкиваемся, когда болеем инфекциями. Отравления некоторыми токсинами мы вполне можем устроить себе самостоятельно: знаменитое похмелье — не что иное, как отравление метаболитами этилового спирта, в первую очередь уксусным альдегидом. И тут с процессом очистки тоже всё понятно: используются методы, неоднократно обкатанные в токсикологии. Чаще всего это различные внутривенные вливания («капельницы») с одновременным форсированием диуреза (выведения веществ с мочой) мочегонными, могут быть задействованы плазмаферез или гемосорбция, иногда приходится проводить и терапию антидотами (противоядиями).
И тут с процессом очистки тоже всё понятно: используются методы, неоднократно обкатанные в токсикологии. Чаще всего это различные внутривенные вливания («капельницы») с одновременным форсированием диуреза (выведения веществ с мочой) мочегонными, могут быть задействованы плазмаферез или гемосорбция, иногда приходится проводить и терапию антидотами (противоядиями).
То есть сами по себе токсины и шлаки — не миф, они известны медицине, хорошо диагностируются, а для борьбы с ними существуют разные методы лечения с подтверждённой эффективностью. Но всё это не имеет отношения к практикам «чистки» или «детоксикации» для здорового человека.
Фотографии: Prostock-studio – stock.adobe.com, chee siong teh – stock.adobe.com
Шлаки и самоотравление. Как помочь организму в самоочистке?
Шлаки и самоотравление. Как помочь организму в самоочистке?
Мы ежедневно моем лицо, но очень редко задумываемся над тем, нужно ли очищать кишечник.
От большого количества жирной пищи, мяса, молочных и других продуктов в организме человека накапливаются пищевые отходы. Если позволить этим остаткам распада пищи накапливаться в кишечнике, то произойдёт аутоинтоксикация (самоотравление) – заболевание, которое возникает от усвоения отходов метаболизма, разложившихся веществ из кишечника или продуктов мертвых и зараженных тканей. Токсины могут переноситься кровью во все части организма и попадать в каждую клетку, вызывая различные формы болезней.
Если Вы испытывали какие-либо из ниже перечисленных симптомов, у Вас, возможно, происходила аутоинтоксикация и поэтому Вам стоит подумать о какой-нибудь программе внутренней очистки.
- Аллергия или непереносимость некоторых продуктов
- Частые простуды, вирусные заболевания
- Скопление газов, частые кишечные заболевания
- Непереносимость жирной пищи
- Низкий уровень энергии, беспричинная слабость
- Боль в нижней части спины
- Пониженная сопротивляемость инфекциям
- Потребность в длительном сне
- Боли в печени или мочевом пузыре
- Проблемы с кожей, сыпь, угри, фурункулы.

Что же такое шлаки? В медицине этим термином обозначают нерастворенные и непереработанные вещества, т.е. патологические образования. Шлаки образуются практически во всех органах: в почках, печени, желчном пузыре, делясь на несколько групп по химическому составу. К шлакам относятся холестериновые бляшки, оседающие внутри сосудов, токсины и отложения солей в позвоночнике и суставах, камни разного вида: печеночные, почечные, желчного и мочевого пузыря, каловые, а также избыток слизи. Самое большое количество шлаков находится в толстом кишечнике, печени и почках – органах выделительной системы.
Одной из важнейших функций нашего организма является его способность к детоксикации и самоочищению. И днём, и ночью в режиме non-stop происходит обезвреживание опасных соединений и их выведение из организма.
Почему надо чистить кишечник?
Врачи самых различных специальностей хорошо знают, что начало многих заболеваний связано с кишечником. А проявиться сбои в работе желудочно-кишечного тракта могут где угодно и как угодно: на коже (дерматит, псориаз, аллергия), в лёгких (бронхиальная астма), в нарушении обмена веществ (ожирение, сахарный диабет, остеохондроз, артрит), в вегето-сосудистой дистонии, хронических запорах и болезнях мочевыводящих путей, частых головных болях и простудных заболеваниях, радикулитах, мигренях. И это далеко не весь список.
И это далеко не весь список.
Особенно вредной является привычка плотно есть на ночь. Сон на голодный желудок – это сеанс детоксикации и очистки кишечника, а плотный ужин превращает ночь в процедуру самоотравления.
К сожалению, большинство людей имеют различные проблемы с кишечником и составом микрофлоры, и для многих людей нарушенная работа кишечника стала привычным состоянием, и они даже не предполагают, насколько это ухудшает здоровье. В связи с чем, очищение кишечника является наилучшим путём для восстановления и сохранения здоровья. Если очищение проводится грамотно, то у большинства людей повышается работоспособность, появляется ощущение лёгкости в теле. Люди ощущают себя внутренне помолодевшими, творческая активность идёт на подъём.
Как помочь организму в самоочистке:
Шаг №1: Пейте воду. Все процессы обмена веществ происходят в водной среде. Вода удаляет отходы из организма и регулирует пищеварение. Недостаток воды тормозит процессы естественной очистки организма и вызывает постоянное самоотравление клеток, тканей и органов. (См. тему «Питьевая вода: кладовая пользы»).
(См. тему «Питьевая вода: кладовая пользы»).
Шаг №2: Употребляйте клетчатку и пищевые волокна. Клетчатка и пищевые волокна обладают уникальной способностью очистки желудочно-кишечного тракта от шлаков. Увеличение клетчатки в нашей диете может быть важным фактором для улучшения общего самочувствия. Поскольку пищевые волокна обладают способностью впитывать много жидкости, они набухают в желудке, заполняют часть его объема – и в результате насыщение происходит быстрее. Дневная потребность в клетчатке составляет 25-35 г. (См. тему «Здоровое питание. Клетчатка»).
Шаг №3: Прекратите есть на ночь. Сон на голодный желудок – это сеанс детоксикации и очистки кишечника.
Шаг №4: Не ешьте жирную, жареную пищу и сладости. Их излишки, смешиваясь с естественной слизью кишечника, превращаются в шлаки и откладываются везде, где только можно.
Список литературы
- Гогулан, М. Законы полноценного питания / М. Гогулан. – М.
 : АСТ: Астрель; Владимир: ВКТ, 2010. – 46 с.
: АСТ: Астрель; Владимир: ВКТ, 2010. – 46 с. - Кольяшкин, М.А. Лечебное питание : домашний справочник / М.А. Кольяшкин, Н.Н. Полушкина. – Ростов н/Д.: Феникс, 2009. – 254 с.
- Литвина, И.И. Три пользы / И.И. Литвина. – М.: Физкультура и спорт, 1989. – 208 с.
- Ноукс, М., Клифтон, П. Еда для долголетия / М. Ноукс, П. Клифтон. – М.: ЗАО «ОЛМА Медиа Групп», 2010. – 224 с.
- Популярно о питании / Под ред. проф. А.И. Столмаковой и канд. мед. наук И.О. Мартынюка. – Киев: Изд-во «Здоровья», 1989. – 272 с.
Правда о шлаках и токсинах
Как часто вы натыкаетесь в интернете на рекламу, которая предлагает очистить организм домашними методами за пару дней? А изгнать ужасные шлаки и токсины, которые не дают вам нормально жить? Согласитесь, все эти страшилки про то, что какие-то вещества в организме отравляют нас изнутри, звучат жутко. Давайте разберёмся, кто такие эти токсины и шлаки, можно ли изгнать их при помощи нетрадиционной медицины, и что скрывают врачи.
1. «Шлаки» – это псевдонаучный термин
Сторонники альтернативной медицины называют «шлаками» вредные вещества, которые копятся у нас в организме и мешают жить полной жизнью. Они предлагают радикальные методы борьбы – клизмы, голодание или употребление лошадиных доз цитрусового сока и оливкового масла.
Труженики официальной медицины отмечают, что у теории шлаков нет никакой доказательной базы и предупреждают о том, что экстремальные методы детоксикации могут нанести непоправимый вред здоровью.
Наш организм – это идеальная система, которой не требуется дополнительная очистка. Если чувствуете недомогание – обратитесь к специалисту, а не покупайте волшебные бутылочки с соками на каждый день.
2. Токсины существуют
Токсины – это яды, которые в некоторых случаях образуются в организме. Но только во время тяжёлой болезни или отравления! В таком случае нужно обратиться к врачу, а не составлять самостоятельно план голодания. Если вы здоровы, токсины не образуются, и чистка кишечника вам никак не поможет, она только навредит.
3. Чем чреваты чистки организма
Если злоупотреблять клизмами для чистки, толстая кишка расслабится и перестанет работать как надо.
Собираетесь регулярно принимать масло и цитрусовый сок? В лучшем случае вы сможете сварить внутри себя мыло из слизи, кислоты и масла. А в худшем – есть шанс закупорить себе желчный проток и лечь на операцию.
А в худшем – есть шанс закупорить себе желчный проток и лечь на операцию.
Частые голодания ведут к истощению организма и усугублению большинства уже имеющихся проблем со здоровьем.
Пожалуйста, перед тем, как начать заниматься нетрадиционной медициной, обратитесь к своему лечащему врачу. Может, вам и не нужно ничего с собой делать? Зачем рисковать и испытывать на себе методы, которые не одобряет большинство специалистов?
Предлагаем прочитать три книги о доказательной медицине и современных врачебных мифах.
3 научно-популярные книги о медицине
«0.
 05 Доказательная медицина»
05 Доказательная медицина»Пётр Талантов
Перед вами уникальная книга о развитии доказательной медицины. Чтобы увлечь читателя, автор не просто пишет о врачебном деле, он рассказывает увлекательные истории. Например, от каких болезней, по мнению врачей-мистиков, помогали ландыш, дикий огурец и шерсть медведя. А ещё о том, кто такие биохакеры и как современные специалисты ищут эликсир бессмертия. Целью создания книги, конечно, было рассказать читателям, что такое доказательная медицина и чем она отличается от альтернативной. Давайте узнаем!«Модицина: тройная доза»
Никита Жуков
Эта книга борется с современными псевдомедицинскими заблуждениями. Вместе с Никитой Жуковым читателям предстоит разобраться с закаливанием и медитацией, а ещё узнать, стоит ли принимать фуфломицины.
«Человек противный»
Йаэль Адлер
Пока мы сидим дома, самое время узнать о том, почему наше тело иногда такое неприятное. А ещё о том, как не заболеть, к какому врачу пойти, если стало нехорошо, и в каком случае в поликлинику идти не надо.Опасные шлаки. 10 признаков, что организм отравлен токсинами
Опасные шлаки. 10 признаков, что организм отравлен токсинамиСовременный мир полон токсинов. Часть из них может скапливаться и в организме. Причем иногда это проходит практически незаметно. Однако все же есть некоторые признаки надвигающейся опасности, которые легко пропустить, считают эксперты.
Выпадение волос
Когда человек ежедневно лишается нескольких десятков волос, это, конечно, не повод бить тревогу. Однако, если процесс стал более интенсивным, стоит задуматься. Есть ряд причин, по которым это происходит, среди которых накопление в организме свинца, мышьяка или таллия. Так, например, таллий может проникать внутрь из-за курения, поэтому важно вовремя обратиться к специалисту, пока выпадение волос не переросло в необратимое облысение.
Есть ряд причин, по которым это происходит, среди которых накопление в организме свинца, мышьяка или таллия. Так, например, таллий может проникать внутрь из-за курения, поэтому важно вовремя обратиться к специалисту, пока выпадение волос не переросло в необратимое облысение.
Запор
Запор, как и другие проблемы с пищеварением, не всегда напрямую можно связать с токсинами. Но эксперты утверждают, что в ряде случаев это результат невозможности желудка переварить различные химические вещества, которые присутствуют в еде. Например, консерванты или акрилаимд, которые могут использоваться при изготовлении чипсов.
Опасные шлаки. 10 признаков, что организм отравлен токсинамиГоловокружение и замедленная реакция
Токсины могут превысить уровень минералов и других веществ, которые питают мозг, в результате вызвав головокружение или замедленную реакцию, невозможность быстро сориентироваться в ситуации. В ряде случаев это привыкли объяснять, например, хроническим недосыпом, но рецидив – уже серьезный сигнал.
Резкий запах от пота
Если сильный запах пота сохраняется даже после того, как человек принял душ и использовал дезодорант, то есть вероятность того, что в организме скопились токсины. Проблема связана с тем, что они образуют газы, которые и выделяются вместе с потом. В этом случае антиперспиранты не помогут.
Опасные шлаки. 10 признаков, что организм отравлен токсинамиБоли в суставах и мышцах
Ноющую боль в мышцах часто связывают с последствиями тренировок, однако, если заметной физической нагрузки на мышцы не было, но они вдруг обратили на себя внимание, возможно, такая реакция была спровоцирована токсинами из-за воспаления тканей.
Пятна на коже
Сыпь и другие дерматологические воспаления могут возникнуть не только из-за аллергии, но и из-за реакции на токсины. Причем, как ни странно, вызвать ее могут даже определенные виды мыла или чистящих средств.
Бессонница
Бессонницу зачастую связывают с исключительно неврологическими проблемами. Однако, как пишет thefoodhealth.com, то же может произойти из-за того, что токсины негативно влияют на работу кортизола – гормона, отвечающего за сон.
Однако, как пишет thefoodhealth.com, то же может произойти из-за того, что токсины негативно влияют на работу кортизола – гормона, отвечающего за сон.
Увеличение веса
Некоторые токсины способны негативно повлиять на обмен веществ, нарушая уровень инсулина. Опасность состоит еще и в том, что прибавка в весе не будет резкой, поэтому следует обратить внимание за здоровье, если лишние килограммы стали тенденцией.
Неприятный запах изо рта
Если невозможно избавиться от резкого неприятного запаха изо рта, то, возможно, дело не в гигиенических проблемах, а в том, что токсины мешают нормальной работе организма. В таком случае они будут накапливаться в крови, что будет только ухудшать ситуацию.
Проблемы с ногтями
Ногти служат значимым индикатором различных проблем со здоровьем, на который многие зачастую не обращают внимание. Трещинки, красные полоски, маленькие вмятины или сколы говорят о том, что организм может быть заполнен токсинами. Проконсультироваться с врачом следует, если ногти стало часто ломаться. Это может случится не только из-за недостатка витаминов, но и, напротив, из-за большого количества вредных веществ.
Проконсультироваться с врачом следует, если ногти стало часто ломаться. Это может случится не только из-за недостатка витаминов, но и, напротив, из-за большого количества вредных веществ.
Опасные шлаки. 10 признаков, что организм отравлен токсинами
Размером с небоскреб. К Земле на бешеной скорости несется опасный астероид
Служба информации cheltv.ru
Скрытые признаки токсинов в организме
Токсины окружают нас и без труда проникают в тело, после этого организму приходится бороться с негативным воздействием, пытаясь сохранить нормальную работу всех органов.
Если токсинов и металлов много, то организм не может справиться с их выведением и начинает активно сигнализировать вам с просьбой о помощи. Ваша задача, в данном случае, не пропустить признаки отравления и быстро принять меры по его ликвидации.
Большая часть вредных веществ проникает в наше тело не из воздуха, а из пищи. Ежедневно, съедая продукты напичканные консервантами, фрукты и овощи выращенные с использованием пестицидов, вы даете организму дополнительную порцию токсинов.
Ежедневно, съедая продукты напичканные консервантами, фрукты и овощи выращенные с использованием пестицидов, вы даете организму дополнительную порцию токсинов.
Воздух и вода хранят в себе немало вредных веществ и отходов способных проникнуть в организм. Кожа тоже способна впитывать токсины, поэтому большая часть косметики нередко снабжает организм дополнительными отравляющими веществами.
Запоры
Первый признак скопления токсинов — это запор. За борьбу с вредными веществами отвечает толстая кишка, она должна не только переработать токсины, но и вывести их из организма путем регулярного опорожнения. Если с этим процессом возникают неполадки, то кишка перестает работать как надо, а вдоль ее стенок налипают шлаки.
Утомляемость
Токсины замедляют работу пищеварительного тракта, а чтобы снабдить все клетки энергией, организм должен быстро получить питательные вещества из пищи. Когда этот процесс замедляется вы часто утомляетесь, у вас пропадает желание что-то делать и вы не высыпаетесь.
Боль в мышцах
Борясь с чрезмерным количеством токсинов и отравляющих веществ, ваш организм постоянно испытывает стресс. При этом все мышцы непроизвольно напрягаются и сдавливают капилляры, мешая крови циркулировать по организму, начинается кислородное голодание.
Повышенное потоотделение
Не справившись с выведением токсинов, кишечник передает эстафету печени, она начинает работать в усиленном режиме, а вы получаете симптомы чрезмерной потливости и жар.
Неприятный запах изо рта
Чрезмерное количество углеводов полученных из пищи вызывают увеличение вредного сахара. А это отличная среда для роста вредных микроорганизмов. Бактерии вырабатывают токсины, которые накапливаются в кишечнике и ротовой полости и вызывают неприятный запах.
Как очистить организм от шлаков
ДЕТОКСРассказывает Сергей Михалкин, специалист по традиционной Аюрведической медицине, мармапрактик и виброакустик, фитооздоровитель и консультант Veda Puls.
Давайте сразу определимся с термином. «Детокс» – сегодня имеет несколько другое значение, по сравнению с классическим понятием.
Классически этот термин означает удаление токсинов (читай ядов), из тела. Конечно, яд в организме – это неминуемая смерть (организм немедленно среагирует рвотой или жидким стулом), поэтому сегодняшний общеупотребительный термин ДЕТОКС явно не совсем об этом. НО.
То, что мы все стараемся вывести из организма, можно считать «мягкими ядами», которые «убивает» нас очень медленно, ускоряя старение, «расшатывая» основные системы и ослабляя органы тела.
Что же является лишним и вредным, что накапливается в нашем теле в силу питания, образа жизни и экологии, и что мы можем и должны периодически удалять из своего тела для сохранения молодости, здоровья и хорошей формы?
«Простые шлаки» — в Аюрведе называется АМА.Образуются в результате неполного или неправильного переваривания пищи. Причины такого неполного переваривания являются нарушения основных правил. К наиболее важным можно отнести следующие нарушения:
К наиболее важным можно отнести следующие нарушения:
- Слишком слабый «огонь пищеварения»
- Употребление неподходящей по конституции пищи или не соответствующей сезонным ритмам природы.
- Употребление одновременно пищи несовместимой между собой
- Избыточное или недостаточное (неполноценное) питание
- Прием пищи в то время, когда предыдущая пища еще не переварилась.
- Слишком поздний или слишком ранний прием пищи – когда организм не готов к перевариванию.
- Использование некачественной пищи – старая, полуфабрикаты, подгнившая, перебродившая и тп
Образование этого вида шлаков практически очень сложно избежать, но критически важным является количество образующейся АМА! Если она образуется в большом количестве и непрерывно, организм не успевает всю ее вывести, и она вовлекается в физиологические процессы в организме. Представляя из себя белую липкую плохо пахнущую массу, АМА опасна тем, что она забивает и блокирует каналы циркуляции, пронизывающие ткани нашего тела, препятствуя нормальному усвоению и трансформации питательных веществ и выводу отходов жизнедеятельности.
В то же время этот вид загрязнения легче всех поддается выведению из нашего тела. Способы выведения обсудим немного позже.
Со временем, если АМА не выводится, она начинает «укореняться» в тканях нашего тела, смешиваясь с физиологическим жидкостями и ОТХОДАМИ (!) жизнедеятельности. Эти шлаки становятся намного более токсичными и это уже второй вид шлаков – в Аюрведе, называемый Амавиша
«Токсичные шлаки» – АМАВИШАПроизводят негативное системное влияние на здоровье, распространяясь и откладываясь в тканях тела по всему организму. Длительное воздействие приводит к патологическим изменениям в органах и тканях человека, приводя к хроническим заболеваниям. И третий источник загрязнения – это токсины, попадающие в наш организм извне. В Аюрведе этот вид токсинов называется Гарвиша
ГАРВИШАЭто вещества, которые являются токсинами еще до попадания в наше тело и содержаться в таких источниках как: экологически грязный воздух, вода, бытовая и промышленная химия, продукты ГМО, консерванты, яды и тд.
Эти химические соединения, сами являясь токсичными, смешиваются с АМА (Простые шлаки) и, что еще более опасно, с АМАВИША (токсичные шлаки), усиливая вредное влияние этих загрязнений.
Из всего этого можно сделать 3 простых вывода:
- Работать над минимизацией образования АМА в организме, не допуская ее накопления
- Накапившиеся АМА и АМАВИША необходимо выводить из тела
- Постараться образовать экологичную среду обитания и использовать максимально экологичные продукты и средства, с которыми контактирует организм.
Возвращаемся к нашей теме – ДЕТОКС – это пункт № 2 нашего списка.
Весна – лучшее время для проведения очистки организма. Сама природа находится в переходном цикле от зимы к лету, организм начинает перестройку «физиологического рисунка» функционирования, что способствует более легкому очищению, но телу необходимо помочь!
Тут самое время вспомнить, что у нас есть еще и эмоции!
Так вот, негативные эмоции, стрессы и переживания тоже загрязняют наше тело, но на более тонком уровне. Это негативно сказывается на энергетической системе человека, на его творческом потенциале и даже на ясности восприятия окружающего мира! Наше тело весной пытается освободиться и от такого вида «токсинов».
Это негативно сказывается на энергетической системе человека, на его творческом потенциале и даже на ясности восприятия окружающего мира! Наше тело весной пытается освободиться и от такого вида «токсинов».
Мы это хорошо знаем, испытывая нестабильность эмоционального фона по весне. Мы хотим очистить пищевой тракт и ткани тела от загрязнения, но если есть внутреннее напряжение, то «зажавшиеся» ткани «не отдадут» то что их наполняет. Необходимо снять напряжение и расслабить мышцы, разжать каналы…
Хватит теории – все вроде бы как ясно! Переходим к практике.
Начнем с вводных.Определите какой из вариантов в большей степени характиризует ваше состояние.
Вариант 1. Я в целом неплохо себя чувствую. Достаточно сил для работы и увлечений, засыпаю легко и сплю глубоким сном (не просыпаюсь ночью до подъема), утром просыпаюсь бодрой и отдохнувшей. Мне всегда понятно что я хочу съесть и перекусы не являются для меня необходимостью.
Вариант 2. Чувтвую небольшой упадок сил, но их хватает на работу и домашние дела. Засыпаю то легко, то с трудом. Утром просыпаюсь отдохнувшей, но хотелось бы большей бодрости и энтузиазма на новый день. В целом мой аппетит меня устраивает, но иногда хочется чего-то, возможно особенного, но это длится недолго.
Вариант 3. Чувствую сильный упадок сил. Даже на работу их едва хватает, а для домашних дел необходимо себя заставлять. Сон часто беспокойный, могу проснуться ночью и тяжело вновь уснуть. Постоянно хочется что-то съесть или вообще не хочется есть (ем, так как необходимо питаться). Часто есть ощущение, что съел бы что-то, но что непонятно.
Прежде чем привести схему «детокса» для разных вариантов, необходимо отметить, что самое правильное – начать с консультации Специалиста Аюрведы. Это позволит определить вашу конституцию (чтобы понимать какие продукты ей соответствуют), определить ваш статус по огню пищеварения (подход при сильном огне и слабом по процедурам и фито поддержке будет серьезно различаться), степень и тип зашлакованности – тут будет ясно: можно ли обойтись домашними средствами и употреблением препаратов или необходимо серьезное профессиональное вмешательство, т. е. проведение очистительных процедур с правильной подготовкой, исполнением и выходом.
е. проведение очистительных процедур с правильной подготовкой, исполнением и выходом.
Выход из процесса очистки играет не меньшую роль, чем само очищение. Мы освобождаем ткани и системы от заполнявших их загрязнений и ВАЖНО напитать и восстановить ткани в здоровом виде, а не наполнить их вновь вредными для здоровья веществами!
Для Варианта 1 — программа длится 7-10 дней. Варианты 2 и 3 — от 2-х недель, максимальная продолжительность будет зависеть от ваших возможностей по процедурам и степени загрязнения.
Методы очистки организма от шлаков и токсинов (Детокс)*
|
пп |
Действие |
Вариант 1 |
Вариант 2 |
Вариант 3 |
|
1 |
Диета |
|||
|
1. |
Легкая диета (разгрузка ЖКТ). Рецепты блюд и рацион |
+ |
|
|
|
1.2. |
Специальная очистительная диета. Рецепты блюд и схема питания |
|
+ |
+ |
|
1.3. |
Прием фито препаратов на поддержание огня пищеварения |
+ |
+ |
+ |
|
1.4. |
Прием фито препаратов на вывод АМА из ЖКТ |
+ |
+ |
+ |
|
2 |
Антистресс |
|||
|
2. |
Дыхательные упражнения, медитация, йога |
+ |
+ |
+ |
|
2.2. |
Антистресс процедура (делаются специалистом) – вибро-акустический массаж, марма терапия |
+ |
+ |
+ |
|
2.3. |
Фито поддержка (по назначению) |
(+) |
+ |
+ |
|
3 |
Промасливание (снаружи и изнутри) – делаем АМА подвижной |
|||
|
3. |
Прием масел (конституционно) внутрь |
+ |
+ |
+ |
|
3.2. |
Промасливание перед душем дома |
+ |
(+) |
(+) |
|
3.3. |
Абхьянга – масляный массаж |
+ |
+ |
(+) |
|
4 |
Очистка каналов тела и тканей |
|||
|
4. |
Фито терапия на вывод АМА и АМАВИША из тела |
(+) |
+ |
+ |
|
4.2. |
Внешние процедуры очистки каналов и тканей (Массаж травяными мешочками, массаж ручной с травами и т.п.) |
(+) |
+ |
+ |
|
4.3. |
Процедура на усиление циркуляции в теле и ускорение вывода токсинов (Пресс-абхьянга) |
(+) |
+ |
+ |
|
5 |
Очистительные процедуры (только по назначению и под контролем) |
|||
|
5. |
Насья (закапывание медицинского масла в нос с массированием) |
(+) |
+ |
+ |
|
5.2. |
Виречена (слабительная процедура) |
|
(+) |
+ |
|
5.3. |
Очистительные клизмы |
|
(+) |
(+) |
|
5.4. |
Ракта мокшана (пиявки) – по рекомендации — гирудотерапевт |
(+) |
(+) |
(+) |
|
6 |
Выход из детокс и омоложение тканей тела |
|||
|
6. |
Диета по разжиганию огня пищеварения и нормализации микробиомы кишечника |
+ |
+ |
+ |
|
6.2. |
Фито поддержка – прием паст восстановления тканей тела и укрепление психоэмоциональной устойчивости |
+ |
+ |
+ |
*Приведенная таблица, носит информационный характер и является ориентировочным порядком действий. Необходимо проконсультироваться со Специалистом.
(+) На ваше усмотрение или по рекомендации Специалиста как оптимальный вариант
Описание некоторых ключевых процедур, их воздействие на тело и разум. Антистресс. Вибро-акустический массаж Тибетской чашей
Антистресс. Вибро-акустический массаж Тибетской чашейОписание
Виброакустический массаж Тибетской чашей снимает тонусы мышц и позволяет расслабить тело.
Эффекты:
- Глубокое расслабление мышц
- Восстановление циркуляции энергии в теле
- Нейтрализация воздействия стрессов
- Способствует хорошему сну и отдыху
- Устранение деструктивных эмоций
- Стимулирование работы эндокринной и иммуной систем
Общий эффект Тибетской целительной чаши
- обладает выраженным нервно-рефлекторным воздействием, вызывая усиление, а иногда и восстановление угасших рефлексов;
- может оказывать выраженное обезболивающее и даже анестезирующее действие;
- улучшает сократительную функцию мышц;
- улучшает трофику тканей, активизируя регенеративные процессы; значительно сокращает сроки образования костной мозоли;
- в зависимости от частоты, силы и амплитуды колебаний вибрация оказывает большое влияние на сердечно-сосудистую систему, вызывая интенсивное расширение или сужение сосудов.

Описание
Комплексное воздействие на все системы и органы, со снятием воздействия стрессов, стимулирование работы кровеносной, лимфатической и эндокринной систем. Поддержка опорно-двигательного аппарата и т.д.
Эффекты:
- Приводит шлаки и токсины в теле в состояние готовности к выводу
- Устраняет дисбаланс свойств тела (Балансирует Доши)
- Нормализует пищеварение – балансируется пищеварительный огонь
- Выводятся токсины, в том числе эмоциональные
- Повышается уровень энергии
- Восстанавливает и омолаживает ткани тела
- Снимает боли, борется с хроническими головными болями
- Достигается глубокая релаксация
Описание
Массаж стоп– отличная мера профилактики заболеваний как опорно-двигательного аппарата, сердечно-сосудистой, нервной систем, так и всех органов в отдельности. Идеален в качестве поддерживающей терапии при лечении практически всех заболеваний На Востоке заслуженно называется «счастье ног»
Идеален в качестве поддерживающей терапии при лечении практически всех заболеваний На Востоке заслуженно называется «счастье ног»
Эффекты:
- Стимулирует работу внутренних органов, систем и желез
- Снимает боли в ногах, спине и суставах
- Способствует улучшению кровообращения и питания органов
- Помогает выведению из организма продуктов обмена и токсинов
- Достигается глубокое расслабление голеностопа.
Описание
Пинда сведана — процедура, при которой применяются порошки лекарственных трав, завернутые в тугие полотняные мешочки (узелки), которые периодически подогреваются в горячем лечебном масле. Тело растирается, массируется и прогревается с помощью этих мешочков.
Эффекты:
- Смягчает и избавляет от боли
- Смягчает воспаления
- Используется при артритах, спондилите и воспалениях
- Очищает тело от токсинов
- Омолаживает
- Снимает напряжение, усталость и слабость
- Улучшает качества кожи, делает её более чувствительной, утончённой и прочной
- Защищает тело от стресса, напряжения и болезней вызванных увеличением ваты
- Улучшает качества сна
- Придаёт тонус и питает ткани тела, укрепляет мышцы и улучшает структуру кожи.

Это массаж всего тела со специальными травяным порошком и маслом. Польза массажа Удвартана:
- Способствует лечению целлюлита и варикоза, улучшает состояние капиллярных сетей, подкожной жировой клетчатки и сосудов.
- Применяется при мышечной дистрофии
- Омоложение (замедление процесса старения)
- Снимает напряжение, усталость, слабость и приостанавливает неправильное развитие мышечной ткани
- Укрепляет и очищает кожу, делает её более чувствительной, утончённой и прочной.
- Придаёт тонус и питает ткани тела, укрепляет мышцы и улучшает структуру кожи, улучшает рельеф кожи, приостанавливает развитие патогенеза.
- Процедура стабилизирует работу всех систем организма
Описание
Воздействие на Марма точки головы и шеи для освобождения от напряжения и эмоциональных блоков. Особенно рекомендован при стрессах, в период экзаменов и отчетов.
Особенно рекомендован при стрессах, в период экзаменов и отчетов.
Эффекты:
- Нейтрализация воздействия стрессов — позволяет расслабиться и снять нервное напряжение
- Способствует хорошему сну и отдыху
- Устранение деструктивных эмоций
- Стимулирет работу эндокринной и иммунной систем
- Настройка центральной нервной системы
- Стимулирование эндокринных желез
- Повышение иммунитета
- Регулируются все энергетические центры мозга
- Нормализуются психоэмоциональная сфера, память и интеллект.
Описание
Марма-терапия является одной из разновидностей аюрведического массажа, это самая древняя из известных ныне техник восполнения жизненной энергии и восстановления обмена веществ. В результате точных и деликатных прикосновений к особым точкам тела (мармам) оказывается энергетическое воздействие на глубинные структуры мозга и эндокринную систему.
Правда о токсинах | Rush System
Сок голодный. Колон очищает. Соляные ванны. Детоксикационные маски для лица. Бесчисленные магазины, веб-сайты и рекламные ролики продают эти и другие продукты, которые, по словам одного крупного продавца, «избавляют ваше тело от токсинов».
Они не пропагандируют детоксикацию, которая является важной частью лечения наркозависимости. Вместо этого они продают решения проблемы, которая «по сути надумана», — говорит Грегори Раух, доктор медицины, врач первичной помощи в Медицинском центре Университета Раша.«Они подразумевают, что в вашем теле есть« токсины », и вы думаете:« Мне нужно избавиться от этих вещей ». Проблема в том, что люди, продающие эти продукты, никогда не упоминают, что это за токсины ».
Это подводит нас к первому, что вам следует знать перед тем, как попробовать какой-либо продукт или программу, обещающую «очистить», «детокс» или «вывести» ваш организм от токсинов:
1. Очищающие и детокс-продукты ничего не делают для удаления токсичных веществ.

Причина, по которой маркетологи, как правило, не определяют «токсины», заключается в том, что обычно нет каких-либо ядовитых веществ, которые эти типы продуктов могут удалить из вашего тела.
«Детоксифицирующее очищающее средство или маска для лица могут удалить грязь с вашей кожи, например мыло, но они не выводят токсины из кровотока», — говорит Раух. «Это неправильная характеристика».
Точно так же очищающие соки могут временно снизить ваш вес или вызвать ощущение пустоты в желудке, но это просто потому, что вы потребляете меньше калорий. На самом деле они ничего не очищают, хотя могут помешать вам получать необходимые питательные вещества и нарушить работу вашего метаболизма.
За пределами узкого круга конкретных назначенных врачом медицинских применений, очищение толстой кишки, будь то таблетки или клизма, не имеет никакой цели. Они могут даже поранить вас (см. № 4 ниже). Те, кто их продает, часто предполагают, что токсичные вещества могут просачиваться в вашу кровь со стулом, особенно если вы страдаете запором. Но эта теория, которую иногда называют аутоинтоксикацией, полностью опровергнута.
Но эта теория, которую иногда называют аутоинтоксикацией, полностью опровергнута.
2. Ваше тело действительно может избавиться от «токсинов» самостоятельно.
К счастью для нас, наши тела уже очень хорошо справляются с избавлением от веществ, которым им не место.
«Хороший пример — ваши легкие», — говорит Раух. «Они, конечно, выдыхают углекислый газ, и у них также есть маленькие волокна, называемые ресничками, которые выталкивают загрязнения наружу. Поэтому, если вы вдыхаете какие-либо частицы, которых там не должно быть, они попадают в ловушку слизи в ресничках, и вы кашляете или кашляете. проглотите, и оно уйдет «. (Среди многих опасностей курения — повреждение ресничек.)
Помимо легких, тремя основными органами, выводящими отходы и вредные вещества, являются печень, почки и толстая кишка.
Ваша толстая или толстая кишка «похожа на самоочищающуюся печь, которая развивалась на протяжении сотен тысяч лет», — объясняет Раух. После того, как ваш тонкий кишечник абсорбирует питательные вещества из того, что вы едите, и отправляет их в кровоток, толстый кишечник избавляется от всего, что остается.
Печень также играет ключевую роль в пищеварении, но она также выполняет многие другие функции. Один из них — фильтрация крови для нейтрализации и избавления от потенциально вредных веществ.«Независимо от того, едите ли вы его, наносите на кожу или вдыхаете — как бы что-то ни попало в ваш кровоток, печень будет его обрабатывать», — объясняет Нэнси Ро, доктор медицины, гепатолог (специалист по печени) в Rush.
Ваши почки также фильтруют вашу кровь, удаляя побочные продукты пищеварения и других процессов организма, производя мочу, которая выводит их из вашего тела.
3. Если токсичные для вашего тела вещества действительно причиняют вам вред, вам нужны проверенные методы лечения.
Иногда, конечно, в этом процессе что-то идет не так.Хотя ваше тело способно безопасно перерабатывать большинство веществ, с которыми вы сталкиваетесь в повседневной жизни, некоторые воздействия могут привести к заболеваниям.
Табачный дым, например, вызывает рак легких и другие заболевания. И вы, вероятно, слышали об асбесте, веществе, которое обычно использовалось в строительстве до 1970-х годов, когда было обнаружено, что он вызывает рак.
И вы, вероятно, слышали об асбесте, веществе, которое обычно использовалось в строительстве до 1970-х годов, когда было обнаружено, что он вызывает рак.
Многие вещества относительно безопасны в небольших количествах, но могут быть вредными в больших количествах. Бокал вина за ужином вряд ли вызовет тошноту, но люди, которые потребляют более трех с половиной порций за ночь, в два-три раза чаще, чем другие, заболевают определенными видами рака.
Если вы считаете, что подверглись воздействию — или подвергаете себя — воздействию веществ, которые могут причинить вам вред, поговорите со своим лечащим врачом. Они порекомендуют соответствующие скрининговые тесты и методы лечения или направят вас к специалисту, который сможет это сделать.
Продукты, продаваемые как средства для очищения печени и почек, действительно могут вызвать нагрузку на органы, которым они призваны помочь.
4. Некоторые «очищающие средства» могут навредить вам.

Избегайте любых продуктов или услуг, которые утверждают, что очищают ваши почки, печень или толстую кишку.Такие продукты малоэффективны и ненужны. Что еще более тревожно, они могут нанести травму.
Очищение толстой кишки с использованием клизм — также известное как ирригация толстой кишки или гидротерапия толстой кишки — может фактически вызвать повреждение толстой кишки.
«Они могут оказать слишком сильное давление на толстую кишку, из-за чего она взорвется, как воздушный шар», — объясняет Раух. Или кончик устройства для клизмы может повредить стенку прямой кишки или анального канала, что приведет к кровотечению, абсцессам и инфекции, для устранения которых иногда требуется хирургическое вмешательство.
Будь то клизма или таблетка, любой вид очищения толстой кишки может привести к обезвоживанию, нарушению баланса электролитов и нарушению естественного уровня кишечных бактерий. Если у вас останется слишком мало «хороших» бактерий, может вырасти слишком много вредных бактерий, что приведет к воспалению толстой кишки.
Точно так же продукты, продаваемые как средства для очищения печени и почек, действительно могут вызывать нагрузку на органы, которым они призваны помочь. «Некоторые из этих средств содержат вещества, которые, как было доказано, способствуют хроническому заболеванию почек из-за содержащихся в них токсинов», — говорит Васил Пеев, доктор медицины, нефролог (специалист по почкам) в Rush.
5. Другие используют обманные уловки.
Некоторые так называемые детоксификаторы выходят за рамки расплывчатых маркетинговых заявлений, явно обманывая потребителей.
Например, некоторые таблетки для очищения толстой кишки содержат полимеры, вещества, которые связываются со стулом и меняют его консистенцию, так что вы в конечном итоге проходите мимо чего-то, что выглядит как длинные серые веревки. А продукты, продаваемые как «детоксицирующие подушечки для ног», содержат химическое вещество, которое становится черным при контакте с потом.
«На самом деле они созданы для того, чтобы заставить людей почувствовать, что что-то удаляется из их тел», — говорит Раух.
6. Вам лучше заняться основной проблемой.
Итак, что вы можете сделать, если чувствуете, что вам нужна хорошая внутренняя очистка?
«Если вы думаете о детоксикации, подумайте вместо этого о глубинной проблеме», — советует Ро. «Если вы просто хотите быть более здоровым, лучше всего выбрать правильную диету и заниматься спортом. А некоторые симптомы, такие как прибавка в весе или утомляемость, должны быть оценены для выявления причин, которые можно устранить».
Например, если вы все время чувствуете усталость, возможно, вы не высыпаетесь.Если вы набираете вес, возможно, вы недостаточно тренируетесь или придерживаетесь сбалансированной диеты. Если у вас запор, вам может помочь употребление большего количества клетчатки и жидкости. Если проблемы не исчезнут, несмотря на ваши усилия по их решению, поговорите со своим лечащим врачом.
«Нет альтернативы здоровому выбору», — говорит Раух. «Как и все остальное, если это звучит слишком хорошо, чтобы быть правдой, вероятно, так оно и есть».
Как токсины вызывают болезнь | Институт естественной медицины
Хотя слово «токсин» звучит устрашающе, большинство людей не понимают, как именно токсины взаимодействуют с физиологией человека и как долго это было проблемой для людей.Почти двести лет назад врачи заметили, что такие токсины, как ртуть, вызывают «болезнь безумного шляпника». Также было известно, что токсичность от свинцовых водопроводных труб была главной причиной упадка Римской империи. Но в прошлом эти токсины были в значительной степени ограничены профессиональным воздействием.
Известно, что жертвами становятся только люди, выполнявшие определенные задачи — шахтеры, вдыхавшие угольную пыль, например. Врачи не считали остальное население подверженным риску.Но со взрывом промышленной активности и производства продукции все изменилось. После дополнительных исследований ученые и проницательные клиницисты теперь лучше понимают, что токсичность затрагивает большую часть — если не все — население. Чем больше я наблюдаю за исследованиями и чем больше пациентов я наблюдаю, тем больше я убеждаюсь в том, что мы видим только верхушку айсберга.
Чем больше я наблюдаю за исследованиями и чем больше пациентов я наблюдаю, тем больше я убеждаюсь в том, что мы видим только верхушку айсберга.
Как токсины повреждают наш организм
По сути, токсины могут повредить наш организм восемью способами.
Токсины отравляют ферменты , поэтому они не работают должным образом.
Наши тела — это двигатели ферментов. Каждая физиологическая функция зависит от ферментов, которые производят молекулы, производят энергию и создают клеточные структуры. Токсины повреждают ферменты и, таким образом, подрывают бесчисленные функции организма — например, подавляя выработку гемоглобина в крови или снижая способность организма предотвращать повреждение свободными радикалами, которое ускоряет старение.
Токсины вытесняют структурные минералы , в результате чего кости становятся слабее.
Людям необходимо поддерживать здоровую костную массу для передвижения на протяжении всей жизни. Когда токсины вытесняют кальций, присутствующий в костях, возникает двоякий эффект: более слабые структуры скелета и повышенное количество токсинов, выделяемых в результате потери костной массы, которые циркулируют по всему телу.
Когда токсины вытесняют кальций, присутствующий в костях, возникает двоякий эффект: более слабые структуры скелета и повышенное количество токсинов, выделяемых в результате потери костной массы, которые циркулируют по всему телу.
Токсины повреждают органы.
Токсины повреждают почти все ваши органы и системы. Моя книга «Токсиновый раствор» посвящена детоксикационным органам. Если ваш пищеварительный тракт, печень и почки настолько токсичны, что не могут эффективно проводить детоксикацию, ваша детоксикация будет иметь неприятные последствия, и ваше тело останется токсичным.
Токсины повреждают ДНК, что увеличивает скорость старения и дегенерации.
Многие часто используемые пестициды, фталаты, неправильно очищенные эстрогены и продукты, содержащие бензол, повреждают ДНК.
Токсины изменяют экспрессию генов .
Наши гены выключаются и включаются, чтобы адаптироваться к изменениям в нашем теле и внешней среде. Но многие токсины активируют или подавляют наши гены нежелательными способами.
Но многие токсины активируют или подавляют наши гены нежелательными способами.
Токсины повреждают клеточные мембраны , поэтому они не реагируют должным образом.
«Сигнализация» в организме происходит через клеточные мембраны. Повреждение этих мембран не позволяет им получать важные сообщения — например, инсулин не дает клеткам сигнала усвоить больше сахара, или мышечные клетки не реагируют на сигнал магния расслабиться.
Токсины влияют на гормоны и вызывают дисбаланс.
Они индуцируют, подавляют, имитируют и блокируют гормоны. Один пример: мышьяк разрушает рецепторы гормонов щитовидной железы в клетках, поэтому клетки не получают сигнал от гормонов щитовидной железы, которые заставляют их ускорять метаболизм.Результат — необъяснимая усталость.
И последнее, но не менее важное: токсины на самом деле ухудшают вашу способность детоксикации — и это самая страшная проблема из всех.
Когда вы очень токсичны и отчаянно нуждаетесь в детоксикации, это сделать труднее, чем когда вы , а не токсичны. Другими словами, именно тогда, когда вам больше всего нужны ваши системы детоксикации (для решения проблем со здоровьем), ваша усердная система детоксикации, скорее всего, будет работать ниже номинальной. Почему? Потому что тяжелая токсическая нагрузка, которую вы уже несете, превысила ваши детокс-возможности.Верно. Чем больше токсинов отягощает ваше тело, тем больше вреда для путей детоксикации вашего тела.
Вот почему восстановление ваших органов детоксикации — а вместе с ними и путей детоксикации — является такой важной задачей (и почему я посвятил этой теме целую книгу «Токсичное решение»). В результате вы можете легко выводить токсины из своего тела.
______________________________________________________________
Доктор Джозеф Пиццорно — основатель Бастирского университета и соавтор книги The Encyclopedia of Natural Medicine . Эта статья была взята из его последней книги, ТОКСИННОЕ РЕШЕНИЕ: Как скрытые яды в воздухе, воде, пище и продуктах, которые мы используем, разрушают наше здоровье, и что мы можем сделать, чтобы это исправить . Авторское право 2017 г., доктор Джозеф Пиццорно.
Эта статья была взята из его последней книги, ТОКСИННОЕ РЕШЕНИЕ: Как скрытые яды в воздухе, воде, пище и продуктах, которые мы используем, разрушают наше здоровье, и что мы можем сделать, чтобы это исправить . Авторское право 2017 г., доктор Джозеф Пиццорно.
Перепечатано с разрешения HarperOne, подразделения HarperCollinsPublishers.
Фото Дрю Хейс на Unsplash
9 способов омоложить свое тело
Детоксикация — или детокс — это популярное модное слово.
Обычно это подразумевает соблюдение определенной диеты или использование специальных продуктов, которые, как утверждается, избавляют ваш организм от токсинов, тем самым улучшая здоровье и способствуя снижению веса.
К счастью, ваше тело хорошо подготовлено к выведению токсинов и не требует для этого специальных диет или дорогих добавок.
Тем не менее, вы можете улучшить естественную систему детоксикации своего тела.
В этой статье объясняются некоторые распространенные заблуждения о детоксикации, а также девять подтвержденных способов омоложения системы детоксикации вашего организма.
Считается, что детокс-диеты выводят токсины из организма, улучшают здоровье и способствуют снижению веса.
Они часто связаны с употреблением слабительных, мочегонных, витаминов, минералов, чая и других продуктов, которые, как считается, обладают детоксикационными свойствами.
Термин «токсин» в контексте детокс-диет имеет нечеткое определение. Обычно он включает в себя загрязняющие вещества, синтетические химические вещества, тяжелые металлы и обработанные пищевые продукты, которые негативно влияют на здоровье.
Однако популярные детокс-диеты редко определяют конкретные токсины, которые они стремятся удалить, или механизм, с помощью которого они якобы устраняются (1).
Более того, нет доказательств, подтверждающих использование этих диет для выведения токсинов или устойчивого снижения веса (2, 3).
В вашем организме есть сложный способ удаления токсинов, который затрагивает печень, почки, пищеварительную систему, кожу и легкие.
Тем не менее, только когда эти органы здоровы, они могут эффективно устранять нежелательные вещества.
Итак, хотя детокс-диеты не делают того, что ваше тело не может сделать само по себе, вы можете оптимизировать естественную систему детоксикации своего тела.
РезюмеХотя детокс-диеты соблазнительны, ваше тело полностью оборудовано для обработки токсинов и других нежелательных веществ.
Более 90% алкоголя метаболизируется в печени (4).
Ферменты печени метаболизируют алкоголь до ацетальдегида, известного канцерогенного химического вещества (5, 6).
Распознавая ацетальдегид как токсин, ваша печень превращает его в безвредное вещество, называемое ацетатом, который позже выводится из организма.
В то время как обсервационные исследования показали, что потребление алкоголя от низкого до умеренного полезно для здоровья сердца, чрезмерное употребление алкоголя может вызвать множество проблем со здоровьем (7, 8, 9).
Чрезмерное употребление алкоголя может серьезно повредить функции печени, вызывая накопление жира, воспаление и рубцевание (10).
Когда это происходит, ваша печень не может нормально функционировать и выполнять свои необходимые задачи, включая фильтрацию отходов и других токсинов из вашего тела.
Таким образом, ограничение или полное воздержание от алкоголя — один из лучших способов сохранить работоспособность системы детоксикации организма.
Органы здравоохранения рекомендуют ограничить употребление алкоголя до одного напитка в день для женщин и двух для мужчин.Если вы в настоящее время не пьете, вам не следует начинать из-за потенциальной пользы для сердца, связанной с употреблением алкоголя от легкой до умеренной (11).
резюмеСлишком большое количество алкоголя снижает способность печени выполнять свои обычные функции, такие как детоксикация.
Обеспечение адекватного и качественного сна каждую ночь является обязательным условием для поддержания здоровья вашего тела и естественной системы детоксикации.
Сон позволяет вашему мозгу реорганизоваться и перезарядиться, а также удалить побочные продукты токсичных отходов, которые накопились в течение дня (12, 13).
Одним из таких отходов является белок, называемый бета-амилоидом, который способствует развитию болезни Альцгеймера (14, 15).
Из-за недостатка сна ваше тело не успевает выполнять эти функции, поэтому токсины могут накапливаться и влиять на несколько аспектов здоровья (16).
Плохой сон связан с краткосрочными и долгосрочными последствиями для здоровья, такими как стресс, беспокойство, высокое кровяное давление, сердечные заболевания, диабет 2 типа и ожирение (17, 18, 19, 20).
Вам следует регулярно спать от семи до девяти часов в сутки, чтобы поддерживать хорошее здоровье (21).
Если вы испытываете трудности с засыпанием или засыпанием ночью, изменение образа жизни, например, соблюдение графика сна и ограничение синего света, излучаемого мобильными устройствами и экранами компьютеров, перед сном, полезны для улучшения сна (22, 23, 24).
сводкаДостаточный сон позволяет вашему мозгу реорганизовывать, перезаряжать и выводить токсины, которые накапливаются в течение дня.
Вода не просто утоляет жажду. Он регулирует температуру вашего тела, смазывает суставы, помогает пищеварению и усвоению питательных веществ, а также выводит токсины из организма, удаляя продукты жизнедеятельности (25).
Клетки вашего тела должны постоянно восстанавливаться, чтобы они функционировали оптимально и расщепляли питательные вещества, чтобы ваше тело могло использовать их в качестве энергии.
Однако в результате этих процессов выделяются отходы — в виде мочевины и углекислого газа — которые причиняют вред, если они накапливаются в крови (26).
Вода переносит эти отходы, эффективно удаляя их при мочеиспускании, дыхании или потоотделении. Таким образом, для детоксикации важно поддерживать правильный уровень гидратации (27).
Адекватная суточная доза воды составляет 125 унций (3.7 литров) для мужчин и 91 унцию (2,7 литра) для женщин. Вам может потребоваться больше или меньше, в зависимости от вашей диеты, места проживания и уровня вашей активности (28).
резюмеВода не только выполняет множество функций в организме, но и позволяет системе детоксикации организма удалять продукты жизнедеятельности из крови.
Считается, что сахар и обработанные пищевые продукты лежат в основе сегодняшних кризисов общественного здравоохранения (29).
Высокое потребление сладких и сильно обработанных пищевых продуктов было связано с ожирением и другими хроническими заболеваниями, такими как болезни сердца, рак и диабет (30, 31, 32).
Эти болезни препятствуют естественному очищению организма от токсинов, нанося вред органам, которые играют важную роль, например, печени и почкам.
Например, высокое потребление сладких напитков может вызвать ожирение печени, состояние, которое негативно влияет на функцию печени (33, 34, 35).
Употребляя меньше нездоровой пищи, вы можете поддерживать здоровье системы детоксикации организма.
Вы можете ограничить количество нездоровой пищи, оставив ее на полке магазина. Отсутствие его на кухне полностью избавляет от соблазна.
Отсутствие его на кухне полностью избавляет от соблазна.
Замена нездоровой пищи более здоровыми продуктами, такими как фрукты и овощи, также является здоровым способом сократить потребление.
РезюмеИзбыточное потребление нездоровой пищи связано с хроническими заболеваниями, такими как ожирение и диабет. Эти состояния могут нанести вред органам, важным для детоксикации, таким как печень и почки.
Антиоксиданты защищают ваши клетки от повреждений, вызываемых молекулами, называемыми свободными радикалами. Окислительный стресс — это состояние, вызванное чрезмерным производством свободных радикалов.
Ваше тело естественным образом производит эти молекулы для клеточных процессов, таких как пищеварение. Однако алкоголь, табачный дым, неправильное питание и воздействие загрязняющих веществ могут вызывать чрезмерное количество свободных радикалов (36).
Вызывая повреждение клеток вашего тела, эти молекулы участвуют в ряде состояний, таких как слабоумие, болезни сердца, болезни печени, астма и некоторые виды рака (37, 38).
Диета, богатая антиоксидантами, может помочь вашему организму бороться с окислительным стрессом, вызванным избытком свободных радикалов и других токсинов, повышающих риск заболевания.
Сосредоточьтесь на получении антиоксидантов из пищи, а не из добавок, которые, по сути, могут увеличить риск определенных заболеваний при приеме в больших количествах (39, 40, 41).
Примеры антиоксидантов включают витамин A, витамин C, витамин E, селен, ликопин, лютеин и зеаксантин.
Ягоды, фрукты, орехи, какао, овощи, специи и напитки, такие как кофе и зеленый чай, содержат одни из самых высоких уровней антиоксидантов (42).
резюмеДиета, богатая антиоксидантами, помогает вашему организму уменьшить ущерб, наносимый свободными радикалами, и может снизить риск заболеваний, которые могут повлиять на детоксикацию.
Здоровье кишечника важно для поддержания здоровья вашей системы детоксикации. Клетки кишечника имеют систему детоксикации и выведения, которая защищает кишечник и организм от вредных токсинов, таких как химические вещества (43).
Хорошее здоровье кишечника начинается с пребиотиков — типа клетчатки, которая питает полезные бактерии в кишечнике, называемые пробиотиками. С пребиотиками ваши полезные бактерии могут производить питательные вещества, называемые короткоцепочечными жирными кислотами, которые полезны для здоровья (44, 45).
Полезные бактерии в кишечнике могут стать неуравновешенными из-за плохих бактерий из-за использования антибиотиков, плохой гигиены полости рта и качества диеты (46, 47, 48).
Следовательно, этот нездоровый сдвиг в бактериях может ослабить вашу иммунную систему и систему детоксикации и повысить риск заболеваний и воспалений (49).
Употребление в пищу продуктов, богатых пребиотиками, может поддерживать здоровье вашей иммунной системы и системы детоксикации. Хорошие пищевые источники пребиотиков включают помидоры, артишоки, бананы, спаржу, лук, чеснок и овес (43).
РезюмеДиета, богатая пребиотиками, поддерживает здоровье пищеварительной системы, что важно для правильной детоксикации и иммунного здоровья.
Для некоторых людей детоксикация — это средство избавления от лишней воды.
Потребление слишком большого количества соли может привести к задержке излишка жидкости в организме, особенно если у вас есть заболевание, поражающее почки или печень, или если вы не пьете достаточно воды.
Это избыточное скопление жидкости может вызвать вздутие живота и сделать одежду неудобной.Если вы обнаружите, что потребляете слишком много соли, вы можете избавиться от лишнего веса воды.
Хотя это может показаться нелогичным, увеличение потребления воды — один из лучших способов избавиться от лишнего веса воды из-за потребления слишком большого количества соли.
Это потому, что когда вы потребляете слишком много соли и недостаточно воды, ваше тело выделяет антидиуретический гормон, который не позволяет вам мочиться и, следовательно, вывести токсины (50).
Увеличивая потребление воды, ваше тело снижает секрецию антидиуретического гормона и увеличивает мочеиспускание, выводя больше воды и отходов (51, 52, 53).
Также помогает увеличение потребления продуктов, богатых калием, которые уравновешивают некоторые эффекты натрия. Продукты, богатые калием, включают картофель, кабачки, фасоль, бананы и шпинат (54).
сводкаСлишком много соли может увеличить задержку воды. Вы можете избавиться от лишней воды и отходов, увеличив потребление воды и продуктов, богатых калием.
Регулярные упражнения — независимо от массы тела — связаны с более продолжительной жизнью и снижением риска многих состояний и заболеваний, включая диабет 2 типа, болезни сердца, высокое кровяное давление и некоторые виды рака (55, 56, 57).
Хотя есть несколько механизмов, лежащих в основе пользы физических упражнений, уменьшение воспаления является ключевым моментом (58, 59).
Хотя некоторое воспаление необходимо для выздоровления от инфекции или заживления ран, слишком большое его количество ослабляет системы вашего тела и способствует развитию болезней.
Уменьшая воспаление, упражнения могут помочь системам вашего организма, включая его систему детоксикации, функционировать должным образом и защитить от болезней.
Рекомендуется выполнять не менее 150–300 минут в неделю упражнений средней интенсивности, таких как быстрая ходьба, или 75–150 минут в неделю физических упражнений высокой интенсивности, например бега (60).
сводкаРегулярная физическая активность снижает воспаление и позволяет системе детоксикации вашего организма работать должным образом.
Хотя в настоящее время нет доказательств, подтверждающих использование детокс-диет для выведения токсинов из вашего тела, определенные изменения в питании и образе жизни могут помочь снизить токсиновую нагрузку и поддержать систему детоксикации вашего организма.
- Ешьте серосодержащие продукты. Продукты с высоким содержанием серы, такие как лук, брокколи и чеснок, усиливают выведение тяжелых металлов, таких как кадмий (61).

- Попробуйте хлореллу. Согласно исследованиям на животных, хлорелла — это тип водорослей, обладающий множеством питательных свойств и способствующий выведению токсинов, таких как тяжелые металлы (62).
- Ароматизатор блюда с кинзой. Кинза усиливает выведение определенных токсинов, таких как тяжелые металлы, такие как свинец, и химикатов, включая фталаты и инсектициды (63, 64).
- Поддержите глутатион. Употребление в пищу продуктов, богатых серой, таких как яйца, брокколи и чеснок, помогает улучшить функцию глутатиона, основного антиоксиданта, вырабатываемого вашим организмом, который активно участвует в детоксикации (65).
- Перейдите на натуральные чистящие средства. Выбор натуральных чистящих средств, таких как уксус и пищевая сода, вместо коммерческих чистящих средств может снизить воздействие потенциально токсичных химикатов (66).
- Выбирайте естественный уход за телом.
 Использование натуральных дезодорантов, макияжа, увлажняющих кремов, шампуней и других средств личной гигиены также может снизить воздействие химических веществ.
Использование натуральных дезодорантов, макияжа, увлажняющих кремов, шампуней и других средств личной гигиены также может снизить воздействие химических веществ.
Хотя многие из этих эффектов были многообещающими, они были продемонстрированы только в исследованиях на животных.Следовательно, для подтверждения этих результатов необходимы исследования на людях.
резюмеНекоторые изменения образа жизни и диеты могут улучшить естественную систему детоксикации вашего организма.
Считается, что детокс-диеты выводят токсины, что, в свою очередь, улучшает здоровье и способствует снижению веса.
Но эти диеты, хотя и соблазнительные, не нужны, поскольку в вашем организме есть собственная высокоэффективная система детоксикации.
Тем не менее, вы можете улучшить естественную систему детоксикации своего организма и улучшить общее состояние здоровья, оставаясь гидратированным, потребляя меньше соли, проявляя активность и соблюдая диету, богатую антиоксидантами.
9 способов омолодить ваше тело
Детоксикация — или детокс — это популярное модное слово.
Обычно это подразумевает соблюдение определенной диеты или использование специальных продуктов, которые, как утверждается, избавляют ваш организм от токсинов, тем самым улучшая здоровье и способствуя снижению веса.
К счастью, ваше тело хорошо подготовлено к выведению токсинов и не требует для этого специальных диет или дорогих добавок.
Тем не менее, вы можете улучшить естественную систему детоксикации своего тела.
В этой статье объясняются некоторые распространенные заблуждения о детоксикации, а также девять подтвержденных способов омоложения системы детоксикации вашего организма.
Считается, что детокс-диеты выводят токсины из организма, улучшают здоровье и способствуют снижению веса.
Они часто связаны с употреблением слабительных, мочегонных, витаминов, минералов, чая и других продуктов, которые, как считается, обладают детоксикационными свойствами.
Термин «токсин» в контексте детокс-диет имеет нечеткое определение. Обычно он включает в себя загрязняющие вещества, синтетические химические вещества, тяжелые металлы и обработанные пищевые продукты, которые негативно влияют на здоровье.
Однако популярные детокс-диеты редко определяют конкретные токсины, которые они стремятся удалить, или механизм, с помощью которого они якобы устраняются (1).
Более того, нет доказательств, подтверждающих использование этих диет для выведения токсинов или устойчивого снижения веса (2, 3).
В вашем организме есть сложный способ удаления токсинов, который затрагивает печень, почки, пищеварительную систему, кожу и легкие.
Тем не менее, только когда эти органы здоровы, они могут эффективно устранять нежелательные вещества.
Итак, хотя детокс-диеты не делают того, что ваше тело не может сделать само по себе, вы можете оптимизировать естественную систему детоксикации своего тела.
РезюмеХотя детокс-диеты соблазнительны, ваше тело полностью оборудовано для обработки токсинов и других нежелательных веществ.
Более 90% алкоголя метаболизируется в печени (4).
Ферменты печени метаболизируют алкоголь до ацетальдегида, известного канцерогенного химического вещества (5, 6).
Распознавая ацетальдегид как токсин, ваша печень превращает его в безвредное вещество, называемое ацетатом, который позже выводится из организма.
В то время как обсервационные исследования показали, что потребление алкоголя от низкого до умеренного полезно для здоровья сердца, чрезмерное употребление алкоголя может вызвать множество проблем со здоровьем (7, 8, 9).
Чрезмерное употребление алкоголя может серьезно повредить функции печени, вызывая накопление жира, воспаление и рубцевание (10).
Когда это происходит, ваша печень не может нормально функционировать и выполнять свои необходимые задачи, включая фильтрацию отходов и других токсинов из вашего тела.
Таким образом, ограничение или полное воздержание от алкоголя — один из лучших способов сохранить работоспособность системы детоксикации организма.
Органы здравоохранения рекомендуют ограничить употребление алкоголя до одного напитка в день для женщин и двух для мужчин. Если вы в настоящее время не пьете, вам не следует начинать из-за потенциальной пользы для сердца, связанной с употреблением алкоголя от легкой до умеренной (11).
резюмеСлишком большое количество алкоголя снижает способность печени выполнять свои обычные функции, такие как детоксикация.
Обеспечение адекватного и качественного сна каждую ночь является обязательным условием для поддержания здоровья вашего тела и естественной системы детоксикации.
Сон позволяет вашему мозгу реорганизоваться и перезарядиться, а также удалить побочные продукты токсичных отходов, которые накопились в течение дня (12, 13).
Одним из таких отходов является белок, называемый бета-амилоидом, который способствует развитию болезни Альцгеймера (14, 15).
Из-за недостатка сна ваше тело не успевает выполнять эти функции, поэтому токсины могут накапливаться и влиять на несколько аспектов здоровья (16).
Плохой сон связан с краткосрочными и долгосрочными последствиями для здоровья, такими как стресс, беспокойство, высокое кровяное давление, сердечные заболевания, диабет 2 типа и ожирение (17, 18, 19, 20).
Вам следует регулярно спать от семи до девяти часов в сутки, чтобы поддерживать хорошее здоровье (21).
Если вы испытываете трудности с засыпанием или засыпанием ночью, изменение образа жизни, например, соблюдение графика сна и ограничение синего света, излучаемого мобильными устройствами и экранами компьютеров, перед сном, полезны для улучшения сна (22, 23, 24).
сводкаДостаточный сон позволяет вашему мозгу реорганизовывать, перезаряжать и выводить токсины, которые накапливаются в течение дня.
Вода не просто утоляет жажду. Он регулирует температуру вашего тела, смазывает суставы, помогает пищеварению и усвоению питательных веществ, а также выводит токсины из организма, удаляя продукты жизнедеятельности (25).
Клетки вашего тела должны постоянно восстанавливаться, чтобы они функционировали оптимально и расщепляли питательные вещества, чтобы ваше тело могло использовать их в качестве энергии.
Однако в результате этих процессов выделяются отходы — в виде мочевины и углекислого газа — которые причиняют вред, если они накапливаются в крови (26).
Вода переносит эти отходы, эффективно удаляя их при мочеиспускании, дыхании или потоотделении. Таким образом, для детоксикации важно поддерживать правильный уровень гидратации (27).
Адекватная суточная доза воды составляет 125 унций (3,7 литра) для мужчин и 91 унцию (2,7 литра) для женщин. Вам может потребоваться больше или меньше, в зависимости от вашей диеты, места проживания и уровня вашей активности (28).
резюмеВода не только выполняет множество функций в организме, но и позволяет системе детоксикации организма удалять продукты жизнедеятельности из крови.
Считается, что сахар и обработанные пищевые продукты лежат в основе сегодняшних кризисов общественного здравоохранения (29).
Высокое потребление сладких и сильно обработанных пищевых продуктов было связано с ожирением и другими хроническими заболеваниями, такими как болезни сердца, рак и диабет (30, 31, 32).
Эти болезни препятствуют естественному очищению организма от токсинов, нанося вред органам, которые играют важную роль, например, печени и почкам.
Например, высокое потребление сладких напитков может вызвать ожирение печени, состояние, которое негативно влияет на функцию печени (33, 34, 35).
Употребляя меньше нездоровой пищи, вы можете поддерживать здоровье системы детоксикации организма.
Вы можете ограничить количество нездоровой пищи, оставив ее на полке магазина. Отсутствие его на кухне полностью избавляет от соблазна.
Замена нездоровой пищи более здоровыми продуктами, такими как фрукты и овощи, также является здоровым способом сократить потребление.
РезюмеИзбыточное потребление нездоровой пищи связано с хроническими заболеваниями, такими как ожирение и диабет.
Эти состояния могут нанести вред органам, важным для детоксикации, таким как печень и почки.
Антиоксиданты защищают ваши клетки от повреждений, вызываемых молекулами, называемыми свободными радикалами. Окислительный стресс — это состояние, вызванное чрезмерным производством свободных радикалов.
Ваше тело естественным образом производит эти молекулы для клеточных процессов, таких как пищеварение.Однако алкоголь, табачный дым, неправильное питание и воздействие загрязняющих веществ могут вызывать чрезмерное количество свободных радикалов (36).
Вызывая повреждение клеток вашего тела, эти молекулы участвуют в ряде состояний, таких как слабоумие, болезни сердца, болезни печени, астма и некоторые виды рака (37, 38).
Диета, богатая антиоксидантами, может помочь вашему организму бороться с окислительным стрессом, вызванным избытком свободных радикалов и других токсинов, повышающих риск заболевания.
Сосредоточьтесь на получении антиоксидантов из пищи, а не из добавок, которые, по сути, могут увеличить риск определенных заболеваний при приеме в больших количествах (39, 40, 41).
Примеры антиоксидантов включают витамин A, витамин C, витамин E, селен, ликопин, лютеин и зеаксантин.
Ягоды, фрукты, орехи, какао, овощи, специи и напитки, такие как кофе и зеленый чай, содержат одни из самых высоких уровней антиоксидантов (42).
резюмеДиета, богатая антиоксидантами, помогает вашему организму уменьшить ущерб, наносимый свободными радикалами, и может снизить риск заболеваний, которые могут повлиять на детоксикацию.
Здоровье кишечника важно для поддержания здоровья вашей системы детоксикации.Клетки кишечника имеют систему детоксикации и выведения, которая защищает кишечник и организм от вредных токсинов, таких как химические вещества (43).
Хорошее здоровье кишечника начинается с пребиотиков — типа клетчатки, которая питает полезные бактерии в кишечнике, называемые пробиотиками. С пребиотиками ваши полезные бактерии могут производить питательные вещества, называемые короткоцепочечными жирными кислотами, которые полезны для здоровья (44, 45).
Полезные бактерии в кишечнике могут стать неуравновешенными из-за плохих бактерий из-за использования антибиотиков, плохой гигиены полости рта и качества диеты (46, 47, 48).
Следовательно, этот нездоровый сдвиг в бактериях может ослабить вашу иммунную систему и систему детоксикации и повысить риск заболеваний и воспалений (49).
Употребление в пищу продуктов, богатых пребиотиками, может поддерживать здоровье вашей иммунной системы и системы детоксикации. Хорошие пищевые источники пребиотиков включают помидоры, артишоки, бананы, спаржу, лук, чеснок и овес (43).
РезюмеДиета, богатая пребиотиками, поддерживает здоровье пищеварительной системы, что важно для правильной детоксикации и иммунного здоровья.
Для некоторых людей детоксикация — это средство избавления от лишней воды.
Потребление слишком большого количества соли может привести к задержке излишка жидкости в организме, особенно если у вас есть заболевание, поражающее почки или печень, или если вы не пьете достаточно воды.
Это избыточное скопление жидкости может вызвать вздутие живота и сделать одежду неудобной. Если вы обнаружите, что потребляете слишком много соли, вы можете избавиться от лишнего веса воды.
Хотя это может показаться нелогичным, увеличение потребления воды — один из лучших способов избавиться от лишнего веса воды из-за потребления слишком большого количества соли.
Это потому, что когда вы потребляете слишком много соли и недостаточно воды, ваше тело выделяет антидиуретический гормон, который не позволяет вам мочиться и, следовательно, вывести токсины (50).
Увеличивая потребление воды, ваше тело снижает секрецию антидиуретического гормона и увеличивает мочеиспускание, выводя больше воды и отходов (51, 52, 53).
Также помогает увеличение потребления продуктов, богатых калием, которые уравновешивают некоторые эффекты натрия.Продукты, богатые калием, включают картофель, кабачки, фасоль, бананы и шпинат (54).
сводкаСлишком много соли может увеличить задержку воды.
Вы можете избавиться от лишней воды и отходов, увеличив потребление воды и продуктов, богатых калием.
Регулярные упражнения — независимо от массы тела — связаны с более продолжительной жизнью и снижением риска многих состояний и заболеваний, включая диабет 2 типа, болезни сердца, высокое кровяное давление и некоторые виды рака (55, 56, 57).
Хотя есть несколько механизмов, лежащих в основе пользы физических упражнений, уменьшение воспаления является ключевым моментом (58, 59).
Хотя некоторое воспаление необходимо для выздоровления от инфекции или заживления ран, слишком большое его количество ослабляет системы вашего тела и способствует развитию болезней.
Уменьшая воспаление, упражнения могут помочь системам вашего организма, включая его систему детоксикации, функционировать должным образом и защитить от болезней.
Рекомендуется выполнять не менее 150–300 минут в неделю упражнений средней интенсивности, таких как быстрая ходьба, или 75–150 минут в неделю физических упражнений высокой интенсивности, например бега (60).
сводкаРегулярная физическая активность снижает воспаление и позволяет системе детоксикации вашего организма работать должным образом.
Хотя в настоящее время нет доказательств, подтверждающих использование детокс-диет для выведения токсинов из вашего тела, определенные изменения в питании и образе жизни могут помочь снизить токсиновую нагрузку и поддержать систему детоксикации вашего организма.
- Ешьте серосодержащие продукты. Продукты с высоким содержанием серы, такие как лук, брокколи и чеснок, усиливают выведение тяжелых металлов, таких как кадмий (61).
- Попробуйте хлореллу. Согласно исследованиям на животных, хлорелла — это тип водорослей, обладающий множеством питательных свойств и способствующий выведению токсинов, таких как тяжелые металлы (62).
- Ароматизатор блюда с кинзой. Кинза усиливает выведение определенных токсинов, таких как тяжелые металлы, такие как свинец, и химикатов, включая фталаты и инсектициды (63, 64).

- Поддержите глутатион. Употребление в пищу продуктов, богатых серой, таких как яйца, брокколи и чеснок, помогает улучшить функцию глутатиона, основного антиоксиданта, вырабатываемого вашим организмом, который активно участвует в детоксикации (65).
- Перейдите на натуральные чистящие средства. Выбор натуральных чистящих средств, таких как уксус и пищевая сода, вместо коммерческих чистящих средств может снизить воздействие потенциально токсичных химикатов (66).
- Выбирайте естественный уход за телом. Использование натуральных дезодорантов, макияжа, увлажняющих кремов, шампуней и других средств личной гигиены также может снизить воздействие химических веществ.
Хотя многие из этих эффектов были многообещающими, они были продемонстрированы только в исследованиях на животных.Следовательно, для подтверждения этих результатов необходимы исследования на людях.
резюмеНекоторые изменения образа жизни и диеты могут улучшить естественную систему детоксикации вашего организма.
Считается, что детокс-диеты выводят токсины, что, в свою очередь, улучшает здоровье и способствует снижению веса.
Но эти диеты, хотя и соблазнительные, не нужны, поскольку в вашем организме есть собственная высокоэффективная система детоксикации.
Тем не менее, вы можете улучшить естественную систему детоксикации своего организма и улучшить общее состояние здоровья, оставаясь гидратированным, потребляя меньше соли, проявляя активность и соблюдая диету, богатую антиоксидантами.
Токсиновый ответ | Гарвардская медицинская школа
Воздействие потенциально вредных химикатов — это реальность жизни. Наши предки, столкнувшись с токсинами природного происхождения, выработали механизмы детоксикации и удаления вредных веществ. В современном мире наш организм регулярно перерабатывает химические вещества, от лекарств и пищевых добавок до сельскохозяйственных и промышленных химикатов, чтобы защитить наши ткани от повреждений.
Как органы, ответственные за метаболизм и выделение токсичных химикатов, печень и почки несут на себе основную тяжесть этого воздействия и подвергаются наибольшему риску повреждения, вызванного токсинами. Понимание того, как эти органы реагируют на токсины или как они повреждаются, имеет особое значение для фармацевтических разработок и исследований в области общественного здравоохранения.
Понимание того, как эти органы реагируют на токсины или как они повреждаются, имеет особое значение для фармацевтических разработок и исследований в области общественного здравоохранения.
Узнайте больше о HMS здесь
Теперь исследователи Гарвардской медицинской школы разработали подход машинного обучения с использованием высококачественных крупномасштабных данных моделей животных, которые проливают новый свет на биологию печени и почек после воздействия токсинов.
Результаты, опубликованные в журнале Molecular Systems Biology в феврале, раскрывают новые механизмы уязвимости и толерантности к токсинам, которые могут иметь широкое отношение к исследованиям болезней человека, говорят авторы.
Их анализ, основанный на общедоступном наборе данных о влиянии 160 различных химических веществ на физиологию, гистопатологию и экспрессию генов у крыс, выявил девять различных паттернов реакции на химическое воздействие, которые авторы назвали «болезненными состояниями». Эти состояния проливают свет на динамику токсин-индуцированного поражения печени и почек, включая защитные механизмы и новые биомаркеры, и дают представление о молекулярных сигналах, которые вызывают индуцированное токсинами подавление аппетита и потерю веса.
Эти состояния проливают свет на динамику токсин-индуцированного поражения печени и почек, включая защитные механизмы и новые биомаркеры, и дают представление о молекулярных сигналах, которые вызывают индуцированное токсинами подавление аппетита и потерю веса.
«Мы использовали машинное обучение, чтобы задать простой вопрос: что мы можем узнать из этого обширного набора данных о том, что происходит с печенью и почками после воздействия различных химических веществ?» сказал ведущий автор исследования Кеничи Шимада, научный сотрудник в области терапевтических наук в лаборатории системной фармакологии в HMS.
Шимада и соавтор Тим Митчисон, профессор системной биологии им. Хасиба Саббаха в Институте Блаватника в HMS, сосредоточили внимание на базе данных Open TG-GATEs, результат 10-летних усилий японского государственно-частного консорциума по оценке 170 различные соединения с целью улучшения и повышения безопасности лекарств.Эти соединения представляют собой широкий спектр химических веществ и лекарств, включая обычные, такие как ибупрофен и ацетаминофен, известные своим токсическим действием на печень и почки в высоких дозах.
Каждое соединение вводили в нескольких дозах и в разные моменты времени крысам, а также клеткам печени крыс и человека, выращенным в культуре. Для каждого из этих условий лечения были собраны различные показатели, включая химический анализ крови, физиологические показатели, такие как масса тела и ткани, гистология и данные экспрессии генов.
Чтобы выявить общие черты и закономерности в реакции печени и почек на различные препараты, Шимада и Митчисон разработали подход машинного обучения без учителя, в котором вычислительный алгоритм — не полагаясь на заранее заданные вопросы, ярлыки или категории, чтобы избежать предвзятости исследователя. — проанализированы данные о 160 соединениях, вводимых крысам, что соответствует более чем 3500 условиям лечения.
Виды травм
Их первоначальный анализ основывался на биохимии крови и данных о массе тела и ткани, которые отражают стандартные клинические тесты, используемые для диагностики пациентов.
Эти анализы выявили девять различных болезненных состояний, каждое из которых представляет собой определенную реакцию на химическое воздействие. Дополнительные компьютерные анализы экспрессии генов и данные гистопатологии — исследования тканей под микроскопом, проводимые патологами, которые также используются в рутинной клинической оценке токсичности, — проливают свет на характеристики каждого болезненного состояния.
Они делятся на две большие категории. Один подход отражал повреждение ткани. Например, воздействие нестероидных противовоспалительных препаратов, таких как ибупрофен, вызывало поздний ответ в печени, связанный с кровотечением, хорошо документированный побочный эффект этих препаратов.Команда увидела образец ответа, отмеченный повышенной экспрессией генов, связанной с воспалением и свертыванием крови, снижением уровней красных кровяных телец и гемоглобина и повышенными маркерами производства красных кровяных телец.
Другие патологические состояния соответствовали паттернам реакций, которые указывали на острое повреждение печени, поражение желчных протоков, повреждение клеток печени и повреждение почек.
Другая группа болезненных состояний отражала нейтральные, неизвестные или даже потенциально полезные реакции.Например, синтетические гормоны запускали паттерн защитной реакции, отмеченный повышенной толерантностью к токсинам. Активность генов, участвующих в метаболизме токсинов, увеличилась, как и биомаркеры, указывающие на повышенную устойчивость к ферроптозу — недавно признанной форме регулируемой гибели клеток, вызванной накоплением побочных продуктов метаболизма.
Допуск перехода
Неожиданно команда обнаружила, что некоторые травмирующие состояния со временем перешли в эту защитную реакцию.Повышенная толерантность к токсинам была тесно связана с повышенной устойчивостью к ферроптозу в печени, но не к другим формам гибели клеток. Лучшее понимание этого процесса может помочь открыть способы борьбы с ферроптозом и улучшить способность печени переносить лекарства.
«Часто пациентам приходится прекращать прием лекарств из-за неблагоприятных побочных эффектов и ждать, пока их организм восстановится, прежде чем они смогут начать снова», — сказал Шимада. «Это дает нам отправную точку для изучения толерантности в контролируемом формате и, возможно, поиска способов улучшить режим дозирования или даже предварительного лечения пациентов, чтобы они могли лучше справляться с токсичностью и меньше травмировать ткани.”
Предложен новый механизм снижения веса тела, вызванного токсинами. Шимада и Митчисон, 2019.Шимада и Митчисон также пролили свет на то, почему потеря веса является такой общей чертой воздействия токсинов, путем анализа генетических и молекулярных биомаркеров наряду с изменениями массы тела.
Они обнаружили, что активность экспрессии инсулиноподобного фактора роста-1 ( Igf1) и трех других связанных генов сильно повышается или понижается. В наборе данных уровень потребления пищи был наиболее сильно связан с массой тела с течением времени, как и ожидалось, что частично можно объяснить ролью этих генов в уровне сахара в крови.По словам авторов, эти сигналы, по-видимому, в совокупности опосредуют общение между органами как часть токсинового ответа.
Команда также идентифицировала ген, Gdf15 , который был связан с подавлением аппетита. Белок, кодируемый этим геном, регулирует питание, воздействуя на рецепторы в стволе мозга. Повышенная активность экспрессии гена Gdf15 , особенно в почках, была последовательной реакцией на повреждение ткани. По словам авторов, этот путь может представлять собой новый механизм подавления аппетита и потери веса, вызванной токсинами, но необходимы дальнейшие исследования, чтобы прояснить его роль.
Поскольку набор данных основан на моделях животных, полученные результаты не могут быть немедленно применимы к людям, сказал Шимада. Кроме того, вычислительные анализы выявили статистические кластеры вызванных токсинами изменений в почках и печени, но не включают другие системы органов и, вероятно, пропускают ответы, уникальные для одного препарата, или не имеют сходства с другими ответами.
Методология и результаты, тем не менее, обеспечивают важную новую информацию о биомаркерах и механизмах, лежащих в основе реакции на токсины, и предлагают основу для будущих исследований, таких как более точные токсикологические исследования на людях, говорят авторы.
«Диагностика заболеваний на основе данных — конечная цель для исследователей, и она абсолютно достижима при наличии доступа к высококачественным данным, как в нашей статье», — сказал Шимада. «Я думаю, что обнаруженные нами биологические особенности и, в частности, механизмы толерантности, при дальнейшем изучении могут дать информацию о стратегиях лечения и, возможно, даже при разработке более эффективных лекарств».
Эта работа была поддержана Японским обществом содействия научным исследованиям за рубежом и Национальными институтами здравоохранения (5P50GM107618).DOI: 10.15252 / msb.20188636
Детоксикация
Восстановите жизненные силы и улучшите здоровье.
- У вас низкий уровень энергии?
- Страдаете ли вы бессонницей?
- У вас есть кожные или сексуальные проблемы?
Ваше тело может быть отягощено высокими уровнями опасных токсинов, которые мешают нормальному функционированию его систем.Токсичные вещества повреждают ДНК и другие клеточные компоненты на молекулярном уровне. Токсины препятствуют правильному усвоению жизненно важных питательных веществ организмом. Это приводит к серьезному химическому дисбалансу в ваших системах организма и может вызвать повреждение тканей и органов. Мы предлагаем терапию ЭДТА (хелатирование) для тяжелых металлов, а также ректально и перорально.
Высокий уровень токсинов в организме может привести к:
- Расстройства настроения
- Сексуальные расстройства
- Проблемы с кожей
- Расстройства пищеварения
- Нарушения сна
- Боли и боли
Организм естественным образом выводит многие токсины самостоятельно, но сегодня мы окружены такими огромными количествами токсинов из окружающей среды, что организм может быть подавлен своей собственной способностью очищать себя.Токсины поступают как из внутренних, так и из внешних источников:
Внешние источники токсинов
- Пестициды
- Гербициды
- Загрязнение
- Экологические токсины
- Кислотный дождь
- Тяжелые металлы
- Рецептурные препараты
- Незаконные наркотики
- Алкоголь
- Сигареты
Внутренние источники токсинов
- Окисление жиров
- Окисление холестерина ,00
- Нарушение функции печени ,00
- Нарушение функции почек ,00
- Свободные радикалы
Детоксикация
Детоксикация — это процесс нейтрализации и вывода токсинов из организма .Детоксикация действует на клеточном уровне и помогает организму использовать свою собственную естественную систему исцеления в борьбе с болезнями. Детоксикация избавляет ваш организм от опасных веществ, восстанавливает жизненные силы и улучшает общее состояние здоровья.
Детоксикация помогает улучшить здоровье, предотвратить болезни и улучшить качество жизни, удаляя опасные токсины из вашего тела и насыщая организм необходимыми питательными веществами.
Детоксикацию следует проводить на регулярной основе для достижения максимального здоровья и оптимизации функционирования вашего организма.
Экспертное лечение
Любое лечение по детоксикации должно проводиться опытным врачом , который сначала оценит ваше текущее состояние здоровья и проведет различные тесты для определения уровня токсичности. Хотя существует множество продуктов для детоксикации, большинство из них просто не работают, а некоторые могут быть опасны для вашего здоровья. Вам следует проконсультироваться со специалистом по детоксикации, чтобы обеспечить оптимальные результаты для здоровья и минимизировать побочные эффекты.
Целостный подход к детоксикации
Детоксикация в сочетании с модификацией образа жизни, диетой и повышенными физическими нагрузками может положительно повлиять на ваше здоровье, улучшить качество жизни, помочь вам выглядеть лучше и чувствовать себя моложе.Необходим комплексный медицинский подход для оптимизации вашего здоровья, обновления уровня энергии и восстановления вашего тела, чтобы вы чувствовали себя на годы моложе. Детоксикация требует целостного подхода, если вы хотите замедлить процесс старения, оставаться здоровым и жить дольше.
Будьте готовы приветствовать вас и свяжитесь с нами сегодняОчистите свой организм от токсинов с помощью натуральных ингредиентов
Недомогание и усталость — две вещи, которые большинство из нас предпочитают не замечать, могут доставить вам массу неприятностей.Знаете ли вы, что основная причина проблем со здоровьем, от которых люди часто страдают, таких как усталость, стресс и бессонница, — это токсины, накопленные в нашем организме? Как токсины, лежащие в основе многих болезней, накапливаются в нашем организме? Каковы симптомы скопления токсинов в организме? Какие органы накапливают токсины больше всего? Какие продукты помогают выводить токсины? Есть продукты, которые очищают ваше тело с головы до пят. Вот ответы на все эти вопросы и список продуктов, очищающих организм от токсинов.
Токсины накапливаются в организме из-за факторов окружающей среды. Токсины часто накапливаются в печени, кишечнике, венах, лимфатических узлах, слюнных железах и легких, закладывая основу для серьезных проблем со здоровьем. Токсины, состоящие из вредных бактерий, которые не позволяют клеткам восстанавливать себя, приводят к нарастанию отека. Некоторые пациенты не осознают, что набирают вес из-за токсинов. В то время как организму нужна печень для удаления токсинов, деформация системы, выводящей токсины из организма, приводит к накоплению токсинов.
Признаки накопления токсинов
Постоянное чувство усталости и бессонницы — один из наиболее частых симптомов накопления токсинов. Истощение, которое вы чувствуете, как только просыпаетесь ото сна, указывает на то, что организм неправильно выводит токсины ночью. В течение дня для снятия усталости пьют такие напитки, как кофе и чай, и такие продукты, как шоколад. Однако чрезмерное потребление этих питательных веществ увеличивает токсины, что приводит к серьезным проблемам в иммунной системе.Метеоризм, несварение желудка, запоры и сильные желудочно-кишечные боли также указывают на токсины. В естественно функционирующей системе организма токсины выводятся из организма при дефекации или мочеиспускании. Однако любая деформация, возникающая здесь, вызывает накопление токсинов.
Ежедневное нарастание головных болей указывает на накопление токсинов, а также на другие заболевания. Это накопление, которое отрицательно сказывается на качестве жизни, мешает нервам легко посылать сигналы телу. Поскольку мозг не может принимать сигналы, это открывает путь к ряду осложнений для здоровья.
Вы можете приготовить полезное печенье с имбирем, которое очистит кровь от токсинов.
Непроизвольное и внезапное увеличение веса также относится к симптомам накопления токсинов. Тело удерживает жир, так как печень не выводит токсины, вызывая региональное увеличение веса. Для выведения из организма вредных для гормональной системы токсинов, вредных для гормональной системы, хорошо обратиться к специалисту.
Поскольку токсины предотвращают повышение уровня гормонов, увеличивается вероятность психических заболеваний.В частности, нервозность, стресс и депрессия возникают из-за недостатка секреции гормонов. Мышцы — одно из мест, где легче всего накапливаются токсины. Накопившиеся в мышцах токсины вызывают спазмы и боли. Это также подготавливает почву для мышечной слабости и мышечных заболеваний.
Токсины — это основа несовершенства кожи. Накопленные в печени токсины вызывают появление прыщей, а также ускоряют старение и образование морщин за счет снижения эластичности кожи.
Продукты для естественной детоксикации
Петрушка и лимон — самые эффективные питательные вещества, выводящие токсины из организма.Специалисты рекомендуют на ночь положить щепотку петрушки и дольки лимона в стакан с теплой водой и выпить на следующее утро перед завтраком.
Капустный сок так же эффективен, как смесь петрушки и лимона. Поскольку вкус капустного сока горький, его можно употреблять, добавив несколько капель лимонного сока. Можно приготовить капусту на пару, взять стакан воды и выпить перед завтраком с несколькими каплями лимонного сока.
Зеленый чай, самый мощный природный антиоксидант, легко выводит токсины, накопленные в организме при мочеиспускании.Вы можете употреблять до двух стаканов зеленого чая в день.
Розмарин эффективно выводит токсины из организма, а также восстанавливает поврежденные клетки. Он удаляет лишний кислород из мозга и сердца и помогает организму нормально функционировать. Специалисты рекомендуют выпивать чашку чая с розмарином в день.
Помидоры, содержащие бета-каротин, ликопин, фолиевую кислоту и витамин А, обладают сильным антиоксидантным действием. Употребление пяти помидоров без гормонов в день помогает вывести из организма все токсины.
Имбирь помогает потовым железам и лимфатической системе, повышая температуру тела и повышая уровень гормонов.




 1.
1. 1.
1. 1.
1. 1.
1. 1.
1.




 Использование натуральных дезодорантов, макияжа, увлажняющих кремов, шампуней и других средств личной гигиены также может снизить воздействие химических веществ.
Использование натуральных дезодорантов, макияжа, увлажняющих кремов, шампуней и других средств личной гигиены также может снизить воздействие химических веществ.
 Эти состояния могут нанести вред органам, важным для детоксикации, таким как печень и почки.
Эти состояния могут нанести вред органам, важным для детоксикации, таким как печень и почки. Вы можете избавиться от лишней воды и отходов, увеличив потребление воды и продуктов, богатых калием.
Вы можете избавиться от лишней воды и отходов, увеличив потребление воды и продуктов, богатых калием.